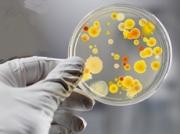
На Ставрополье отмечается неустойчивая эпидемиологическая обстановка по кишечным инфекциям

Архив новостей 03 апреля 2013 г.

Ставропольские власти сохранили за краем право пользования объектами Эшкаконского гидроузла
Заместитель руководителя Федерального агентства по управлению государственным имуществом РФ (Росимущество) Игорь Бабушкин в Ессентуках провел совещани...

Ставропольские судебные приставы покоряют спортивные вершины
Судебные приставы по обеспечению установленного порядка деятельности судов – силовой блок службы, обеспечивающий безопасность не только судей и участн...

Краевая прокуратура выявила около 2 тысяч нарушений прав инвалидов
Прокуратура Ставропольского края провела проверку соблюдения социальных прав инвалидов, в ходе которой выявлены многочисленные нарушения...

В Ставрополе набирают популярность бесплатные юридические клиники при вузах
По данным пресс-службы мэрии, с начала этого года в Ставрополе направления на бесплатные консультации в юридические клиники при вузах получили уже 36...

Кубок России по спортивному ориентированию стартовал на Ставрополье
В Пятигорске стартовал Кубок России по спортивному ориентированию. Более 150 спортсменов из 40 регионов страны в течение двух дней будут оспаривать по...

Кафе в парках Ставрополя в новом сезоне повысят уровень обслуживания
В комитете муниципального заказа и торговли администрации города прошло совещание по вопросу организации работы летних площадок с оказанием услуг пита...

Сотрудники Госавтоинспекции задержали в Ставрополе опасного вооруженного преступника
3 апреля в районе Западного обхода краевого центра сотрудники ОГИБДД Управления МВД России по Ставрополю заметили бегущего молодого человека, который...

С 6 апреля в Ставрополе стартуют ярмарки «Выходного дня»
Первая в этом году ярмарка «Выходного дня» в Ставрополе пройдет в субботу, 6 апреля, по ул. Ленина, 328/11. Об этом сообщает пресс-служба администраци...

Куми-Куми - Серии 1-8 (2012-2013/DVD5)
Добро пожаловать на Куми-Куми — чудесные острова с прекрасными ландшафтами, на которых живут сказочные существа — племена Юми, Шуми и Джуми...

Звезды КВН обсудили с парламентариями края перспективы межрегиональной лиги «Кавказ»
В комитете Думы Ставропольского края по культуре, молодежной политике, физической культуре и средствам массовой информации прошла встреча со звездами...
На Ставрополье отмечается неустойчивая эпидемиологическая обстановка по кишечным инфекциям
Эпидемиологическую обстановку по кишечным инфекциям в крае можно охарактеризовать как неустойчивую, заявила пресс-служба краевого Минздрава в среду...

Сотрудники полиции предотвратили еще одну массовую драку в Ставрополе
2 апреля в отделение полиции №2 Управления МВД России по Ставрополю поступило сообщение о том, что возле одного из торговых центров города собралась г...

Глава администрации Ставрополя распорядился привести после зимы город в порядок
На улицах Ставрополя появится новая праздничная иллюминация. Об этом на еженедельной планерке сообщил глава администрации краевого центра. Улицы Доват...

Ставропольские энергетики внедряют в эксплуатацию более безопасные провода нового поколения
В течение двух лет в рамках инвестиционной программы филиал ОАО «МРСК «Северного Кавказа» - «Ставропольэнерго» проводил реконструкцию существующих сет...

Английский по скайпу – инновационный метод обучения
Сегодня одной из самых востребованных услуг является изучение английского по скайпу. Такой метод обучения, благодаря ряду преимуществ, вытесняет тради...

Игры Скуби Ду – лучший способ развлечься
Современные дети и подростки уже не так любят проводить свободное время во дворах, устраивая различные игры. Сейчас их внимание привлекают онлайн-игры...

Micaela Schaefer: эротическая фотосессия в честь католической Пасхи (ФОТО)
29-летняя немецкая модель Микаэла Шефер (Micaela Schaefer) порадовала всех почитателей своей красоты новыми эротическими снимками на фоне архитектурно...

В Ставрополе пройдет встреча для пожилых людей
В рамках празднования Всемирного дня здоровья в Ставрополе пройдет встреча для пожилых людей «Активное долголетие».Организует ее управление труда, соц...

Татуировка на страже вашего здоровья
Ученые Университета Иллинойса разработали устройство, которое после фиксации на голую кожу человека будет передавать данные о состоянии его здоровья л...

Как определить - аллергия или простуда?
Аллергия или простуда? Иногда это очень трудно определить. Симптомы аллергии могут быть очень похожи на симптомы обычной простуды, но есть некоторые в...

На Ставрополье появился первый инфомат
В селе Летняя Ставка Туркменского района установлено первое на Ставрополье устройство самообслуживания – мобильный инфомат. Еще два десятка подобных у...

Седокова назвала истинные причины развода
Известие о том, что брак певицы Анны Седоковой и бизнесмена Максима Черновицына начал разрушаться появилось сразу после того, как Максима поймали в об...

За 3 месяца в сфере ЖКХ выявлено 2727 нарушений
За 3 месяца 2013 года прокуратурой края в жилищно-коммунальной сфере выявлено 2 727 нарушений законов, в целях устранения которых внесено 388 представ...

В Ставрополе подвели первые итоги работы казачьих классов в школах Ставрополя
В школе №41 краевого центра состоялось заседание круглого стола на тему «Итоги первого этапа работы по организации классов казачьей направленности в о...

Как младший сын Валерия Золотухин отреагировал на его смерть?
Гражданская супруга актера Валерия Золотухина Ирина Линдт дала откровенное интервью уже после смерти любимого человека. В нем Ирина постаралась расска...

Нервный срыв Олеси Судзиловской
Актриса Олеся Судзиловская никогда не страдала невостребованностью. Несмотря на успешную карьеру, в домашнем быту она также преуспевает всегда. После...

Любовник Булановой: Я сделал Тане предложение
Известная певица Татьяна Буланова еще совсем недавно не могла и представить, что гармоничная семейная жизнь превратится в склоки и скандалы, а отношен...

Депрессия Лаймы Вайкуле не позволяет ей нормально жить
Прославленная певица Лайма Вайкуле в последнее время совершенно не рада жизни. Затянувшаяся депрессия не позволяет ей вести привычный образ жизни. Осо...

Певица Юлия Михальчик впервые стала мамой
Известная российская певица, являющаяся выпускницей "Фабрики звезд", Юлия Михальчик впервые стала счастливой мамой.В конце минувшего года в прессе п...

Надежда Грановская беременна третьим ребенком
Одна из самых узнаваемых бывших участниц девичьего коллектива "ВИА Гра" Надежда Грановская неоднократно говорила, что готова выйти замуж за своего г...

Вера Брежнева откровенно о замужестве и детях
Популярная певица Вера Брежнева откровенно признается, что минувший год выдался для нее едва ли не самым сложным за всю жизнь...

Асмус променяла Харламова на Соколовского?
Еще не успели утихнуть страсти вокруг романа актрисы Кристины Асмус и юмориста Гарика Харламова, как девушка дала новую пищу для размышлений...

Охлобыстин рассказал о загульной молодости
В настоящее время Иван Охлобыстин почти у всех ассоциируется в примерным семьянином, который всегда думает о своих родных и близких, стараясь заработа...

Гарик Харламов угодил в аварию в День дурака
В День смеха один из самых узнаваемых резидентов Comedy Club Гарик Харламов совершенно не веселился, когда с ним приключилась неприятность на дороге...

Блистательный Филипп Киркоров надел свадебное платье
Уже становится привычным, что отечественных знаменитостей приглашают на Неделю моды не только в качестве гостей, но и как моделей...

Андрею Панину присвоена "Ника"
Знаменитому актеру Андрей Панин, который трагически скончался в марте этого года, посмертно присвоена кинопремия "Ника" в номинации "лучшая мужская...

Как самому избавиться от боли?
Начнем с того, что боль это сигнал о возникших проблемах. Поэтому от болей в животе или в желудке не стоит избавляться. Нужно вызывать неотложку или...

Человеческому организму не нужно много сахара
ВОЗ рекомендует следующие нормы потребления сладкого в день: для женщин 50 г (до 12 чайных ложек), для мужчин 60 г (до 14 чайных ложек)...

Группа учёных из Италии обнаружила "врата в ад"
Группой учёных из Италии (Italy) была обнаружена очень древняя пещера, именно через неё, освободившиеся от тел души перемещались в потусторонний мир (...